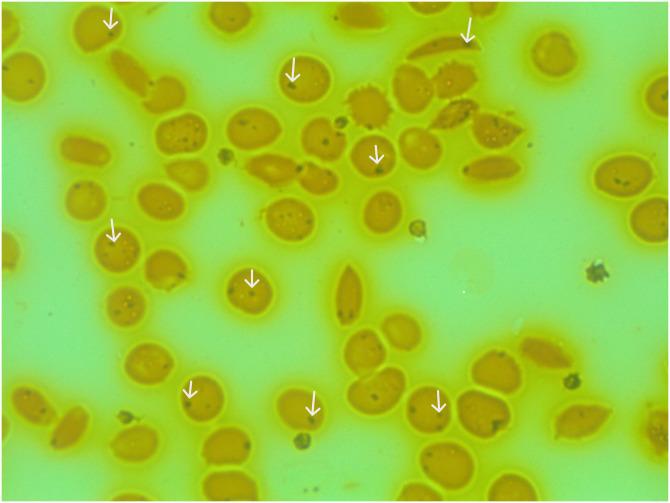

尼日利亚东北部镰状细胞病患者中两种红细胞包涵体染色方法评估脾脏功能的研究
Evaluation of two red cell inclusion staining methods for assessing spleen function among sickle cell disease patients in North-East Nigeria.
作者信息
Ladu Adama I, Satumari Ngamarju A, Abba Aisha M, Abulfathi Fatima A, Jeffery Caroline, Adekile Adekunle, Bates Imelda
机构信息
Department of International Public Health, Liverpool School of Tropical Medicine, Liverpool, United Kingdom.
Department of Haematology, Faculty of Basic Clinical Sciences, University of Maiduguri, Maiduguri, Borno State, Nigeria.
出版信息
PLOS Glob Public Health. 2023 May 18;3(5):e0001552. doi: 10.1371/journal.pgph.0001552. eCollection 2023.
The loss of splenic function is associated with an increased risk of infection in sickle cell disease (SCD); however, spleen function is rarely documented among SCD patients in Africa, due partly to the non-availability of sophisticated techniques such as scintigraphy. Methods of assessing splenic function which may be achievable in resource-poor settings include counting red blood cells (RBC) containing Howell Jolly Bodies (HJB) and RBC containing silver-staining (argyrophilic) inclusions (AI) using a light microscope. We evaluated the presence of HJB-and AI-containing RBC as markers of splenic dysfunction among SCD patients in Nigeria. We prospectively enrolled children and adults with SCD in steady state attending outpatient clinics at a tertiary hospital in North-East Nigeria. The percentages of HJB-and AI-containing red cells were estimated from peripheral blood smears and compared to normal controls. There were 182 SCD patients and 102 healthy controls. Both AI- and HJB-containing red cells could be easily identified in the participants blood smears. SCD patients had a significantly higher proportion of red cells containing HJB (1.5%; IQR 0.7%-3.1%) compared to controls (0.3%; IQR 0.1%-0.5%) (P <0.0001). The AI red cell counts were also higher among the SCD patients (47.4%; IQR 34.5%-66.0%) than the control group (7.1%; IQR 5.1%-8.7%) (P < 0.0001). The intra-observer reliability for assessment of HJB- (r = 0.92; r2 = 0.86) and AI- containing red cells (r = 0.90; r2 = 0.82) was high. The estimated intra-observer agreement was better with the HJB count method (95% limits of agreement, -4.5% to 4.3%; P = 0.579).We have demonstrated the utility of light microscopy in the assessment of red cells containing-HJB and AI inclusions as indices of splenic dysfunction in Nigerian SCD patients. These methods can be easily applied in the routine evaluation and care of patients with SCD to identify those at high risk of infection and initiate appropriate preventive measures.
在镰状细胞病(SCD)中,脾脏功能丧失与感染风险增加相关;然而,在非洲的SCD患者中,脾脏功能很少被记录,部分原因是缺乏诸如闪烁扫描等复杂技术。在资源匮乏地区可以实现的评估脾脏功能的方法包括使用光学显微镜计数含有豪-乔小体(HJB)的红细胞和含有银染色(嗜银)包涵体(AI)的红细胞。我们评估了尼日利亚SCD患者中含有HJB和AI的红细胞的存在情况,以此作为脾脏功能障碍的标志物。我们前瞻性地招募了尼日利亚东北部一家三级医院门诊就诊的处于稳定期的SCD儿童和成人。从外周血涂片估计含有HJB和AI的红细胞百分比,并与正常对照进行比较。共有182例SCD患者和102名健康对照。在参与者的血涂片中可以很容易地识别出含有AI和HJB的红细胞。与对照组(0.3%;四分位间距0.1%-0.5%)相比,SCD患者中含有HJB的红细胞比例显著更高(1.5%;四分位间距0.7%-3.1%)(P<0.0001)。SCD患者中AI红细胞计数也高于对照组(47.4%;四分位间距34.5%-66.0%)(7.1%;四分位间距5.1%-8.7%)(P<0.0001)。评估含有HJB(r = 0.92;r2 = 0.86)和AI的红细胞时,观察者内可靠性很高。HJB计数法的估计观察者内一致性更好(一致性界限95%,-4.5%至4.3%;P = 0.579)。我们已经证明光学显微镜在评估含有HJB和AI包涵体的红细胞作为尼日利亚SCD患者脾脏功能障碍指标方面的实用性。这些方法可以很容易地应用于SCD患者的常规评估和护理,以识别那些感染风险高的患者并采取适当的预防措施。